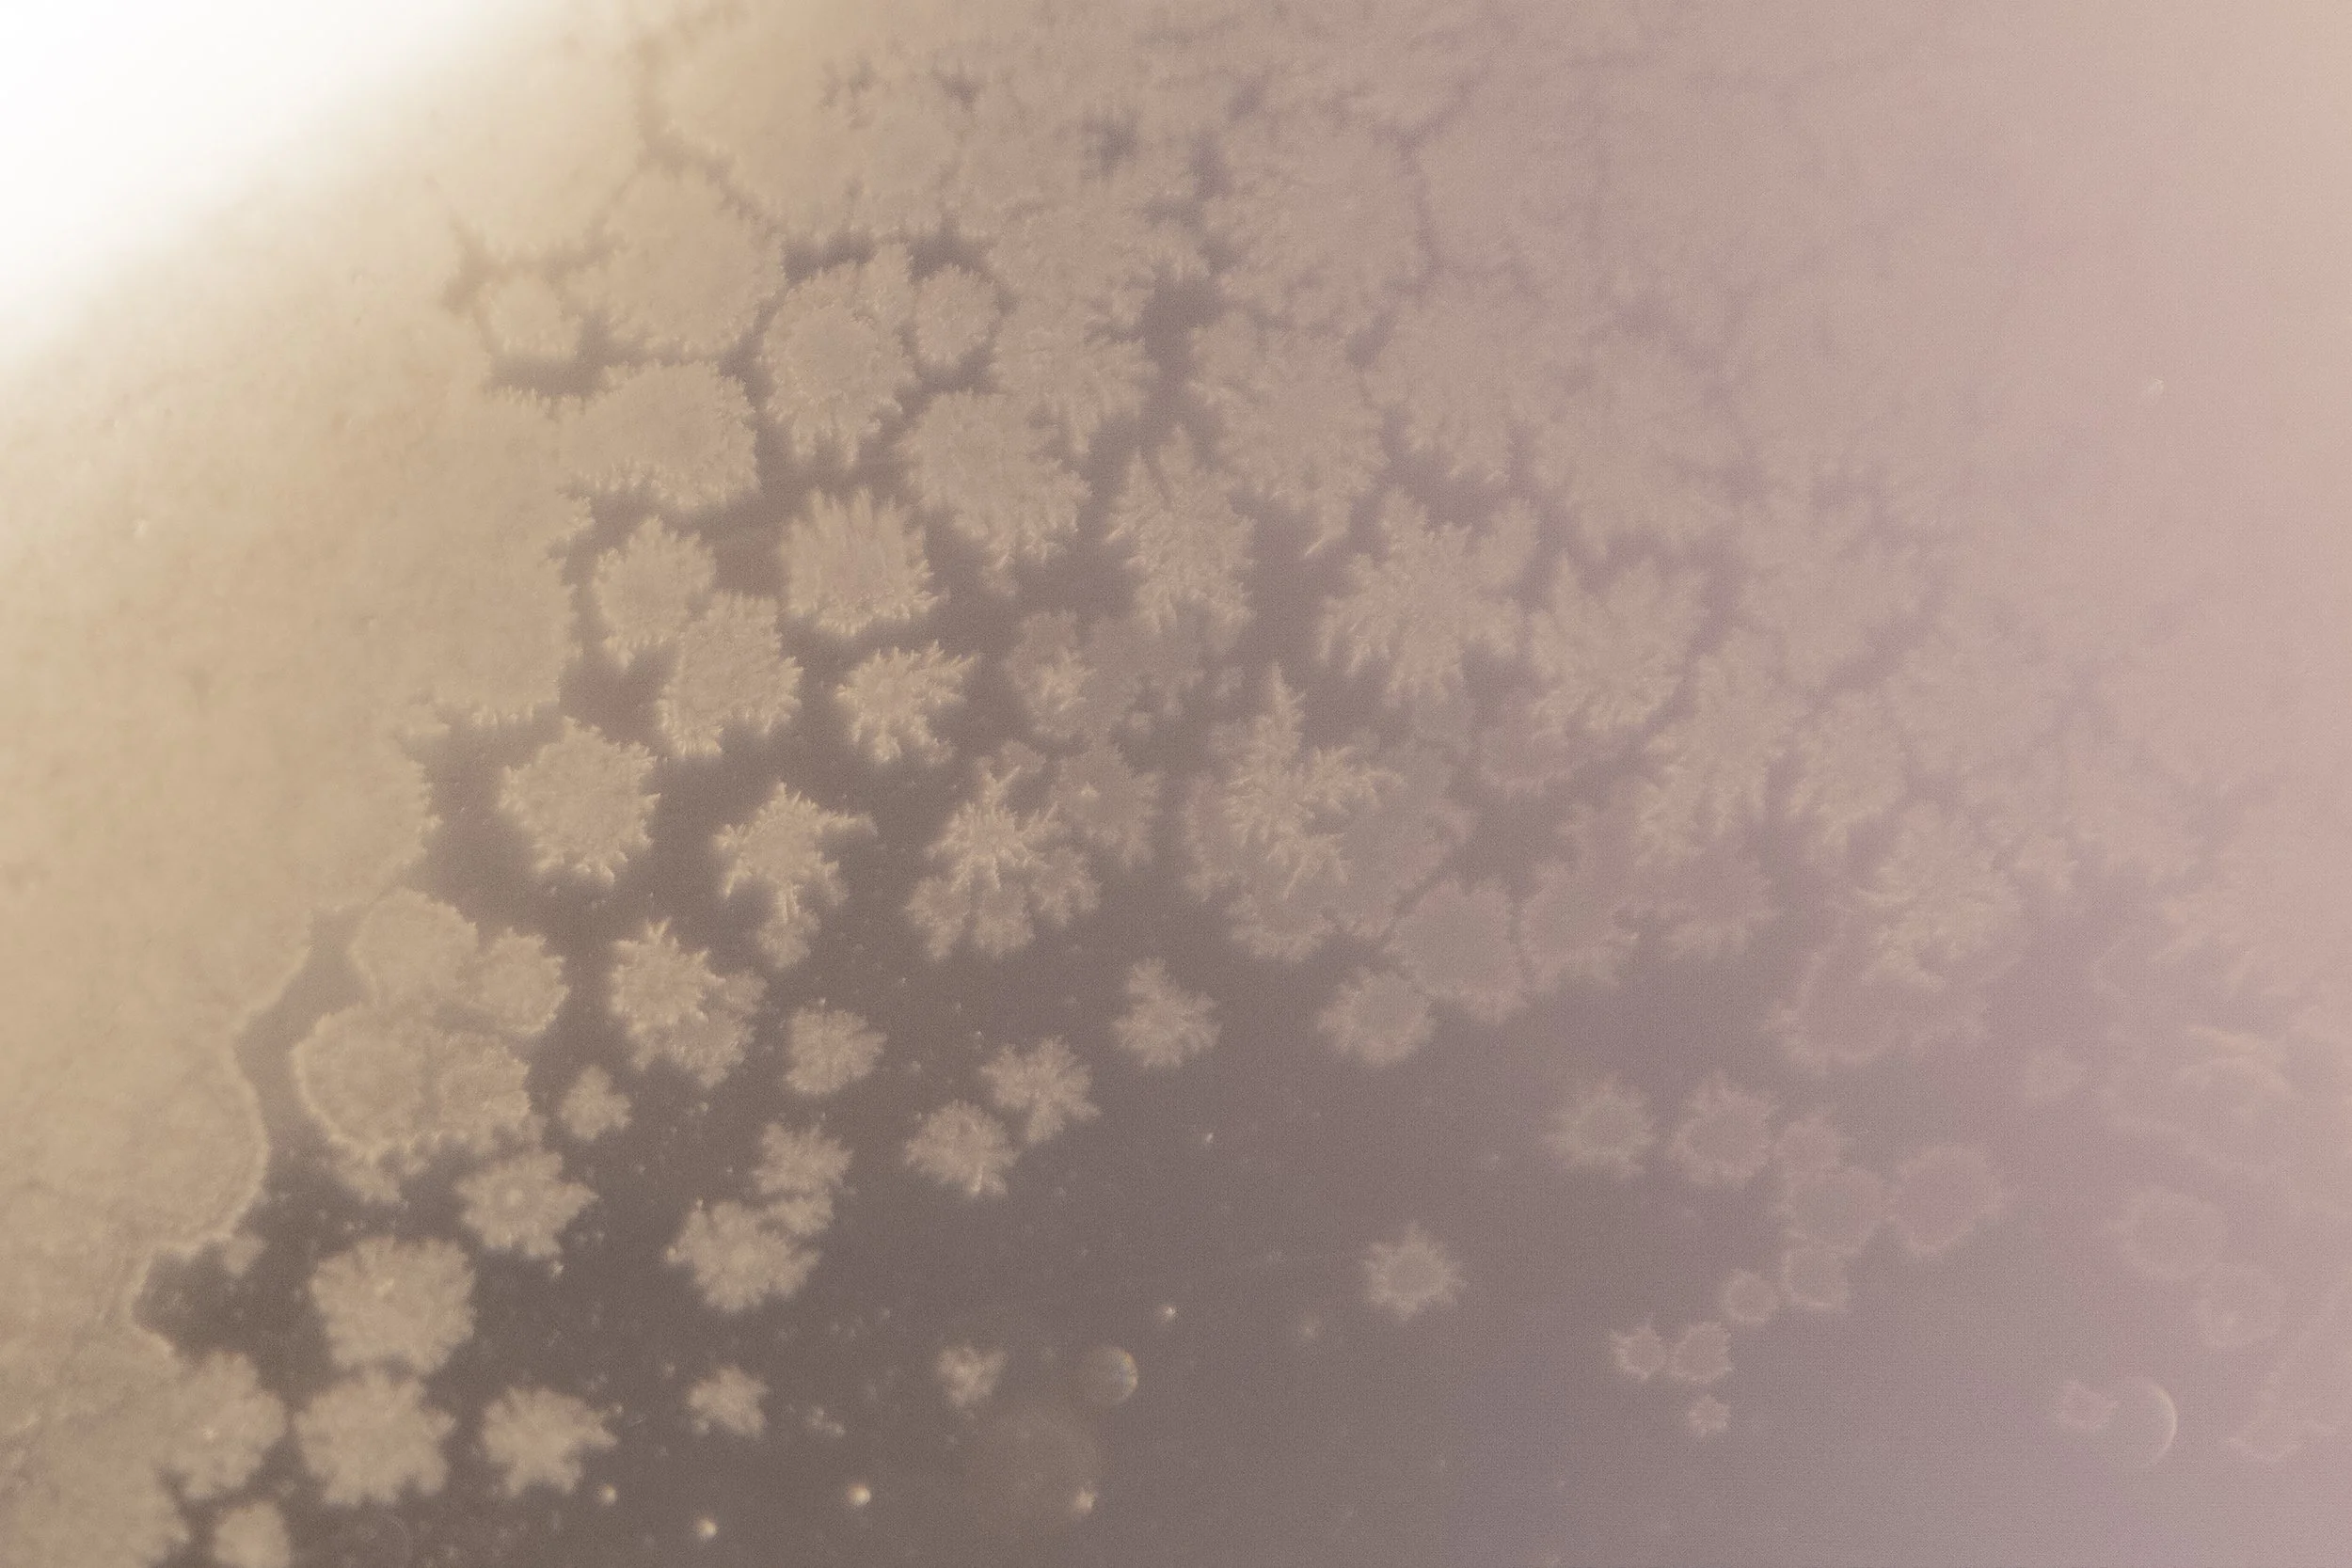

CLARA G.CANO
Psicóloga en Chamberí, Madrid
La terapia integradora, también conocida como terapia integrativa, es un enfoque terapéutico que busca combinar y aprovechar lo mejor de diferentes teorías, técnicas y enfoques terapéuticos en una sola práctica coherente y personalizada. El objetivo principal de la terapia integradora es brindar un enfoque terapéutico más completo y efectivo, adaptado a las necesidades específicas de cada individuo.
Además, desde esta perspectiva, se considera a la persona en su totalidad, incluyendo sus pensamientos, emociones, comportamientos, cuerpo, relaciones, historia de vida y entorno.
¿Qué es la psicoterapia Integradora?
Imagen: Carlo Urbino, Codex Huygens

Psicología Somática Madrid
“ La vida en su mejor momento es un proceso fluido y cambiante en el que nada es fijo”
-Carl RogersMétodos de Acompañamiento
Abordo la terapia desde un enfoque humanista integrador, considerando que todos poseemos los recursos necesarios para poder elaborar nuestro dolor y entender el síntoma. Mi trabajo consiste en generar un espacio seguro (a través del vínculo, de la confianza y del respeto) para que la persona pueda aprender a reconocer sus necesidades internas y pueda ponerlas en el mundo. Para ello empleo diferentes técnicas que trabajan los tres dominios: cognitivo, emocional y conductual para generar una experiencia de integración y conseguir así una mayor coherencia entre lo que sentimos, pensamos y hacemos.
Psicoterapia Verbal
El uso de la palabra dentro de la terapia ayuda a dar sentido e integrar las experiencias, y así ordenar y expresar el lugar donde estamos desde lo cognitivo.
Arteterapia
La experiencia de la creación artística facilita la expresión de estados emocionales de los que podemos no tener una conciencia clara. Además el soporte físico externo de la creación permite tomar cierta distancia de dicho estado emocional, pudiendo entender y dar forma a cuestiones inconclusas de nuestro inconsciente. Así conseguimos expresar de forma creativa nuestro mundo interior y encontrar símbolos propios para poder dar sentido a nuestra experiencia vital.
Conciencia Corporal
El uso de técnicas corporales (respiración, mindfulness, escáner corporal…) hoy en día esta muy consolidado y cada vez hay más literatura científica que lo avala. Considero esencial introducirlo dentro de las sesiones para aprender a regular el sistema nervioso, entrenar la atención y aumentar la interocepción (percepción de los órganos internos) y la propiocepción (percepción del movimiento y la postura corporales), directamente ligadas con aspectos de nuestra psique, entendiendo el cuerpo como metáfora del inconsciente y la reconexión con este como forma de sanación.

Servicios
-
-
Un encuentro mensual para habitar el silencio, dejar que el cuerpo hable y permitir que el gesto revele lo que aún no tiene palabras.
Presencial en Madrid
Escríbeme para más info!

Psicóloga en Chamberí, Madrid
Acompañamiento terapéutico en ansiedad, trauma y procesos emocionales
Reserva una primera sesión conmigo y empieza a cuidar tu bienestar











